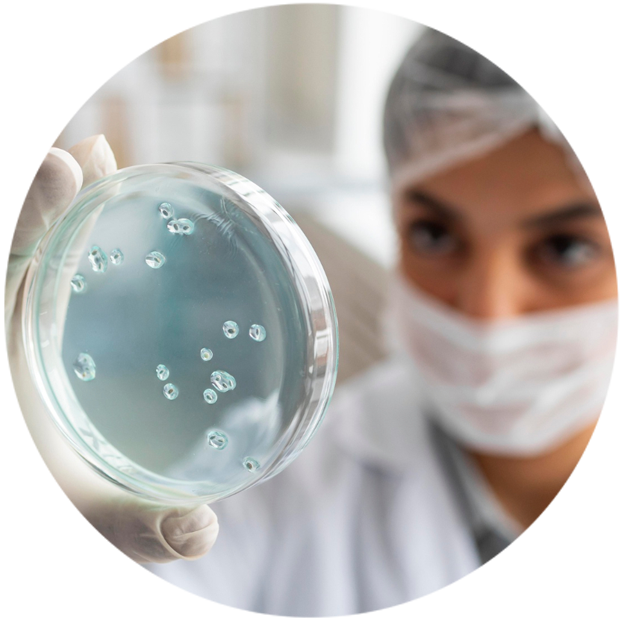

Services
We offer a comprehensive range of advanced scientific, analytical, and research support services designed to meet the needs of students, researchers, and industries across the life sciences domain. Our state-of-the-art facilities, expert team, and high-precision methodologies ensure accurate results, reliable data, and exceptional quality.

Lifescience PhD Assistance Services
We offer end-to-end PhD assistance for research scholars in the life sciences domain. Support includes topic selection, proposal development, experimental design, lab work guidance, data analysis, manuscript preparation, and publication support—ensuring a smooth and structured research journey.
Lifescience Workstation for PhD/MPhil Services
ur dedicated Life Science Workstations provide fully equipped lab access for PhD and MPhil scholars. Researchers can utilize modern instruments, expert guidance, and a supportive research environment to carry out experiments efficiently and successfully.